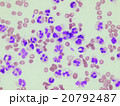
血液 血液 20792487

ダムボさんのプロフィール
自然観察が好きですので、それに関係がある素材を扱っていきたいと思います。
性別
男性
受賞歴
- ございません
ジャンル
生物系から初めて行きたいと思っております。
リンク
- 細かな情報はブログにて解説していきたいと思っておりますので、宜しくどうぞ
- http://heiannityoumevet.blog.so-net.ne.jp/
コメント
はじめは細かいものから紹介いたしますので、ご興味ございましたらご連絡下さい。
TOPの写真はアオムキミジンコです。有名な映画の装甲服に見えるところが気にいっています。ストックフォトではまじめな写真をご紹介しますのでご安心下さい。
ブログにてご紹介しています写真でPIXTAにないものでもお気軽にお問い合わせください。
可能でしたら、PIXTAにてアップいたします。
(動画しかないものもございますのでご了承ください。)